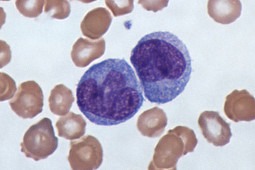

22.07.2013
Autor:
Marzena Jaskot
Źródło: Furlan JC, Vergouwen MDI, Fang J i Silver FL. White blood cell count is an independent predictor of outcomes after acute ischaemic stroke. Eur J Neurol 2013; early view; doi: 10.1111/ene.12233
Stężenie leukocytów a niepełnosprawność i śmiertelność pacjentów po udarze mózgu
Furlan i wsp. wykazali, że w grupie 8829 pacjentów z ostrym niedokrwiennym udarem mózgu podwyższone stężenie leukocytów we krwi było niezależnym czynnikiem ryzyka: ciężkości udaru, niepełnosprawności i zgonu.
Furlan i wsp. odnieśli się do wcześniejszych badań [1,2], z których wynikało, że stężenie leukocytów we krwi żylnej jest związane z gorszymi wynikami leczenia, a także większą objętością niedokrwionej tkanki ośrodkowego układu nerwowego. Zaprojektowali oni analizę, której celem było sprawdzenie, czy podwyższone stężenie leukocytów jest związane z kliniczną ciężkością udaru mózgu, a także stopniem wynikającej z niego niepełnosprawności oraz ryzykiem zgonu. Uwzględniono w niej dane dotyczące 8829 pacjentów z ostrym niedokrwiennym udarem mózgu. Autorzy zdefiniowali małe, średnie i duże stężenia leukocytów ustanawiając dwie wartości progowe: 4 G/L i 10 G/L. W analizach statystycznych pod uwagę brano wpływ potencjalnych czynników zakłócających. Wykazano, że zwiększenie stężenia leukocytów we krwi o 1 G/L było związane ze wzrostem ciężkości mierzonej Kanadyjską Skalą Neurologiczną o 9%. O 7% zwiększało się przy tym ryzyko zgonu w 30 dniach po udarze, a o 4% ryzyko niepełnosprawności określonej jako wynik w zmodyfikowanej skali Rankina od 3 do 6. Autorzy stwierdzili, że podwyższone stężenie leukocytów we krwi jest w ostrym niedokrwiennym udarze mózgu niezależnym czynnikiem ryzyka: ciężkości udaru, niepełnosprawności i zgonu.
1. Buck BH, Liebeskind DS, Saver JL, i wsp. Early neutrophilia is associated with volume of ischemic tissue in acute stroke. Stroke 2008; 39:355-360.
2. Grau AJ, Boddy AW, Dukovic DA, i wsp.. Leukocyte count as an independent predictor of recurrent ischemic events. Stroke 2004; 35:1147-1152.
1. Buck BH, Liebeskind DS, Saver JL, i wsp. Early neutrophilia is associated with volume of ischemic tissue in acute stroke. Stroke 2008; 39:355-360.
2. Grau AJ, Boddy AW, Dukovic DA, i wsp.. Leukocyte count as an independent predictor of recurrent ischemic events. Stroke 2004; 35:1147-1152.
Kategorie:
Udary mózgu





